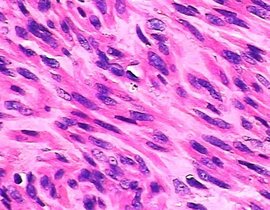
he染色

子宫内膜间质肉瘤来源于子宫内膜间质细胞肿瘤。根据肿瘤的组织学和临床特征将其分为低度恶性子宫内膜间质
子宫内膜间质肉瘤是来源于子宫内膜间质细胞的肿瘤。根据肿瘤的组织学和临床特征将其分为2类,即低度恶性
子宫内膜间质肉瘤根据恶性程度不同分为低度恶性和高度恶性两种。有的医生主张术后辅以放疗,也有医生认为对
子宫间质肉瘤,4月21日剖腹产,同时发现子宫内有肉瘤及腹膜后赘生物,病理报告为:低级别子宫内膜间质肉瘤
医学百科条目“子宫内膜间质肉瘤”是一篇关于子宫内膜间质肉瘤的病因、症状、病理、诊断、治疗的文章,全文
子宫内膜间质肉瘤1期;子宫间质肉瘤;低级别子宫内膜间质肉瘤;120ask医生团队为您解答子宫间质肉瘤的健康
子宫内膜间质肉瘤;子宫内膜间质肉瘤预后如何?一般能活多少年;子宫内膜间质肉瘤1期;120ask医生团队为您
子宫内膜间质肉瘤是女性很少见的一种妇科肿瘤,属于恶性肿瘤,对女性的危害很大,沈阳新时代妇产医院的妇科

子宫肉瘤_360百科
1350x760 - 51KB - JPEG

炎症性单形性未分化肉瘤
270x202 - 28KB - JPEG

七旬老翁眉心长肉瘤 8岁练功今可吊重百斤(图
241x400 - 18KB - JPEG

江苏东海成功摘除一巨型子宫肌瘤
550x418 - 82KB - JPEG

美媒:古人类化石惊现恶性肿瘤 系最早癌症证据
595x393 - 24KB - JPEG

温宏武
220x320 - 12KB - JPEG
he染色
270x210 - 22KB - JPEG